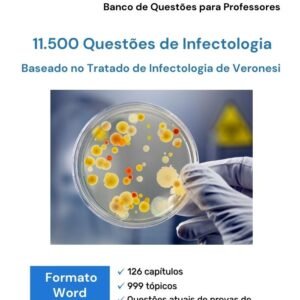
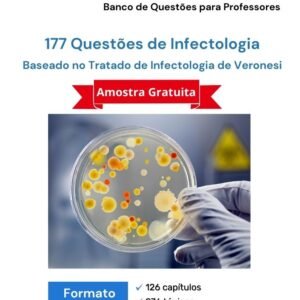

Infectologia
Bancos de questões sobre infectologia.
Exibindo 1–12 de 16 resultados
- Infectologia
1483 Questões de Infectologia Pediátrica (911 comentadas)
R$ 229,90 Adicionar ao carrinhoAvaliação 0 de 5Banco de Questões niveladas por dificuldade, organizado em 22 capítulos e 125 tópicos segundo o Tratado da SBP.
- Infectologia
1483 Questões de Infectologia Pediátrica (911 comentadas)
R$ 189,90 Adicionar ao carrinhoAvaliação 0 de 5Banco de Questões niveladas por dificuldade, organizado em 22 capítulos e 125 tópicos segundo o Tratado da SBP.
- Infectologia
1600 Questões de Infectologia em Word para download
R$ 149,90 Adicionar ao carrinhoAvaliação 0 de 5Organizadas segundo o Tratado de Infectologia de Veronesi (2015) e distribuidas em 126 capítulos e +950 tópicos.
- Infectologia
2411 Questões de Infectologia (1220 comentadas) em Word
R$ 299,90 Adicionar ao carrinhoAvaliação 0 de 5Banco de Questões niveladas por dificuldade e organizado em 131 capítulos e 981 tópicos segundo o Tratado de Infectologia.
- Infectologia
2578 Questões de Infectologia Pediátrica (1593 comentadas)
R$ 339,90 Adicionar ao carrinhoAvaliação 0 de 5Banco de Questões niveladas por dificuldade, organizado em 22 capítulos e 125 tópicos segundo o Tratado da SBP.
- Infectologia
2578 Questões de Infectologia Pediátrica (1593 comentadas)
R$ 299,90 Adicionar ao carrinhoAvaliação 0 de 5Banco de Questões niveladas por dificuldade, organizado em 22 capítulos e 125 tópicos segundo o Tratado da SBP.
- Infectologia
3200 Questões de Infectologia em Word para download
R$ 229,90 Adicionar ao carrinhoAvaliação 0 de 5Organizadas segundo o Tratado de Infectologia de Veronesi (2015) e distribuidas em 126 capítulos e +950 tópicos.
- Infectologia
7541 Questões de Infectologia (4266 comentadas) em Word
Avaliação 0 de 5R$ 799,90O preço original era: R$ 799,90.R$ 699,90O preço atual é: R$ 699,90. Adicionar ao carrinhoBanco de Questões niveladas por dificuldade e organizado em 131 capítulos e 981 tópicos segundo o Tratado de Infectologia.
- Infectologia
Banco de Questões – Infectologia (Word) – 11500
Avaliação 0 de 5R$ 699,90O preço original era: R$ 699,90.R$ 599,90O preço atual é: R$ 599,90. Adicionar ao carrinhoBanco de Questões MED com mais de 11000 questões sobre Infectologia, organizadas de acordo com o Tratado de Infectologia (Veronesi-Foccacia).
- Infectologia
Banco de Questões – Infectologia (Word) – 19000
Avaliação 0 de 5R$ 799,90O preço original era: R$ 799,90.R$ 699,90O preço atual é: R$ 699,90. Adicionar ao carrinhoBanco de Questões MED com mais de 19000 questões sobre Infectologia, organizadas de acordo com o Tratado de Infectologia (Veronesi-Foccacia)
.
- Infectologia
Banco de Questões – Infectologia (Word) – 6500
Avaliação 0 de 5R$ 455,00O preço original era: R$ 455,00.R$ 389,90O preço atual é: R$ 389,90. Adicionar ao carrinhoBanco de Questões MED com mais de 6000 questões sobre Infectologia, organizadas de acordo com o Tratado de Infectologia (Veronesi-Foccacia)
.
- Infectologia
Banco de Questões – Infectologia (Word) Amostra Grátis
R$ 0,00 Adicionar ao carrinhoAvaliação 0 de 5Banco de Questões de amostra contendo 177 questões sobre Infectologia, organizadas de acordo com o Tratado de Infectologia (Veronesi-Foccacia).